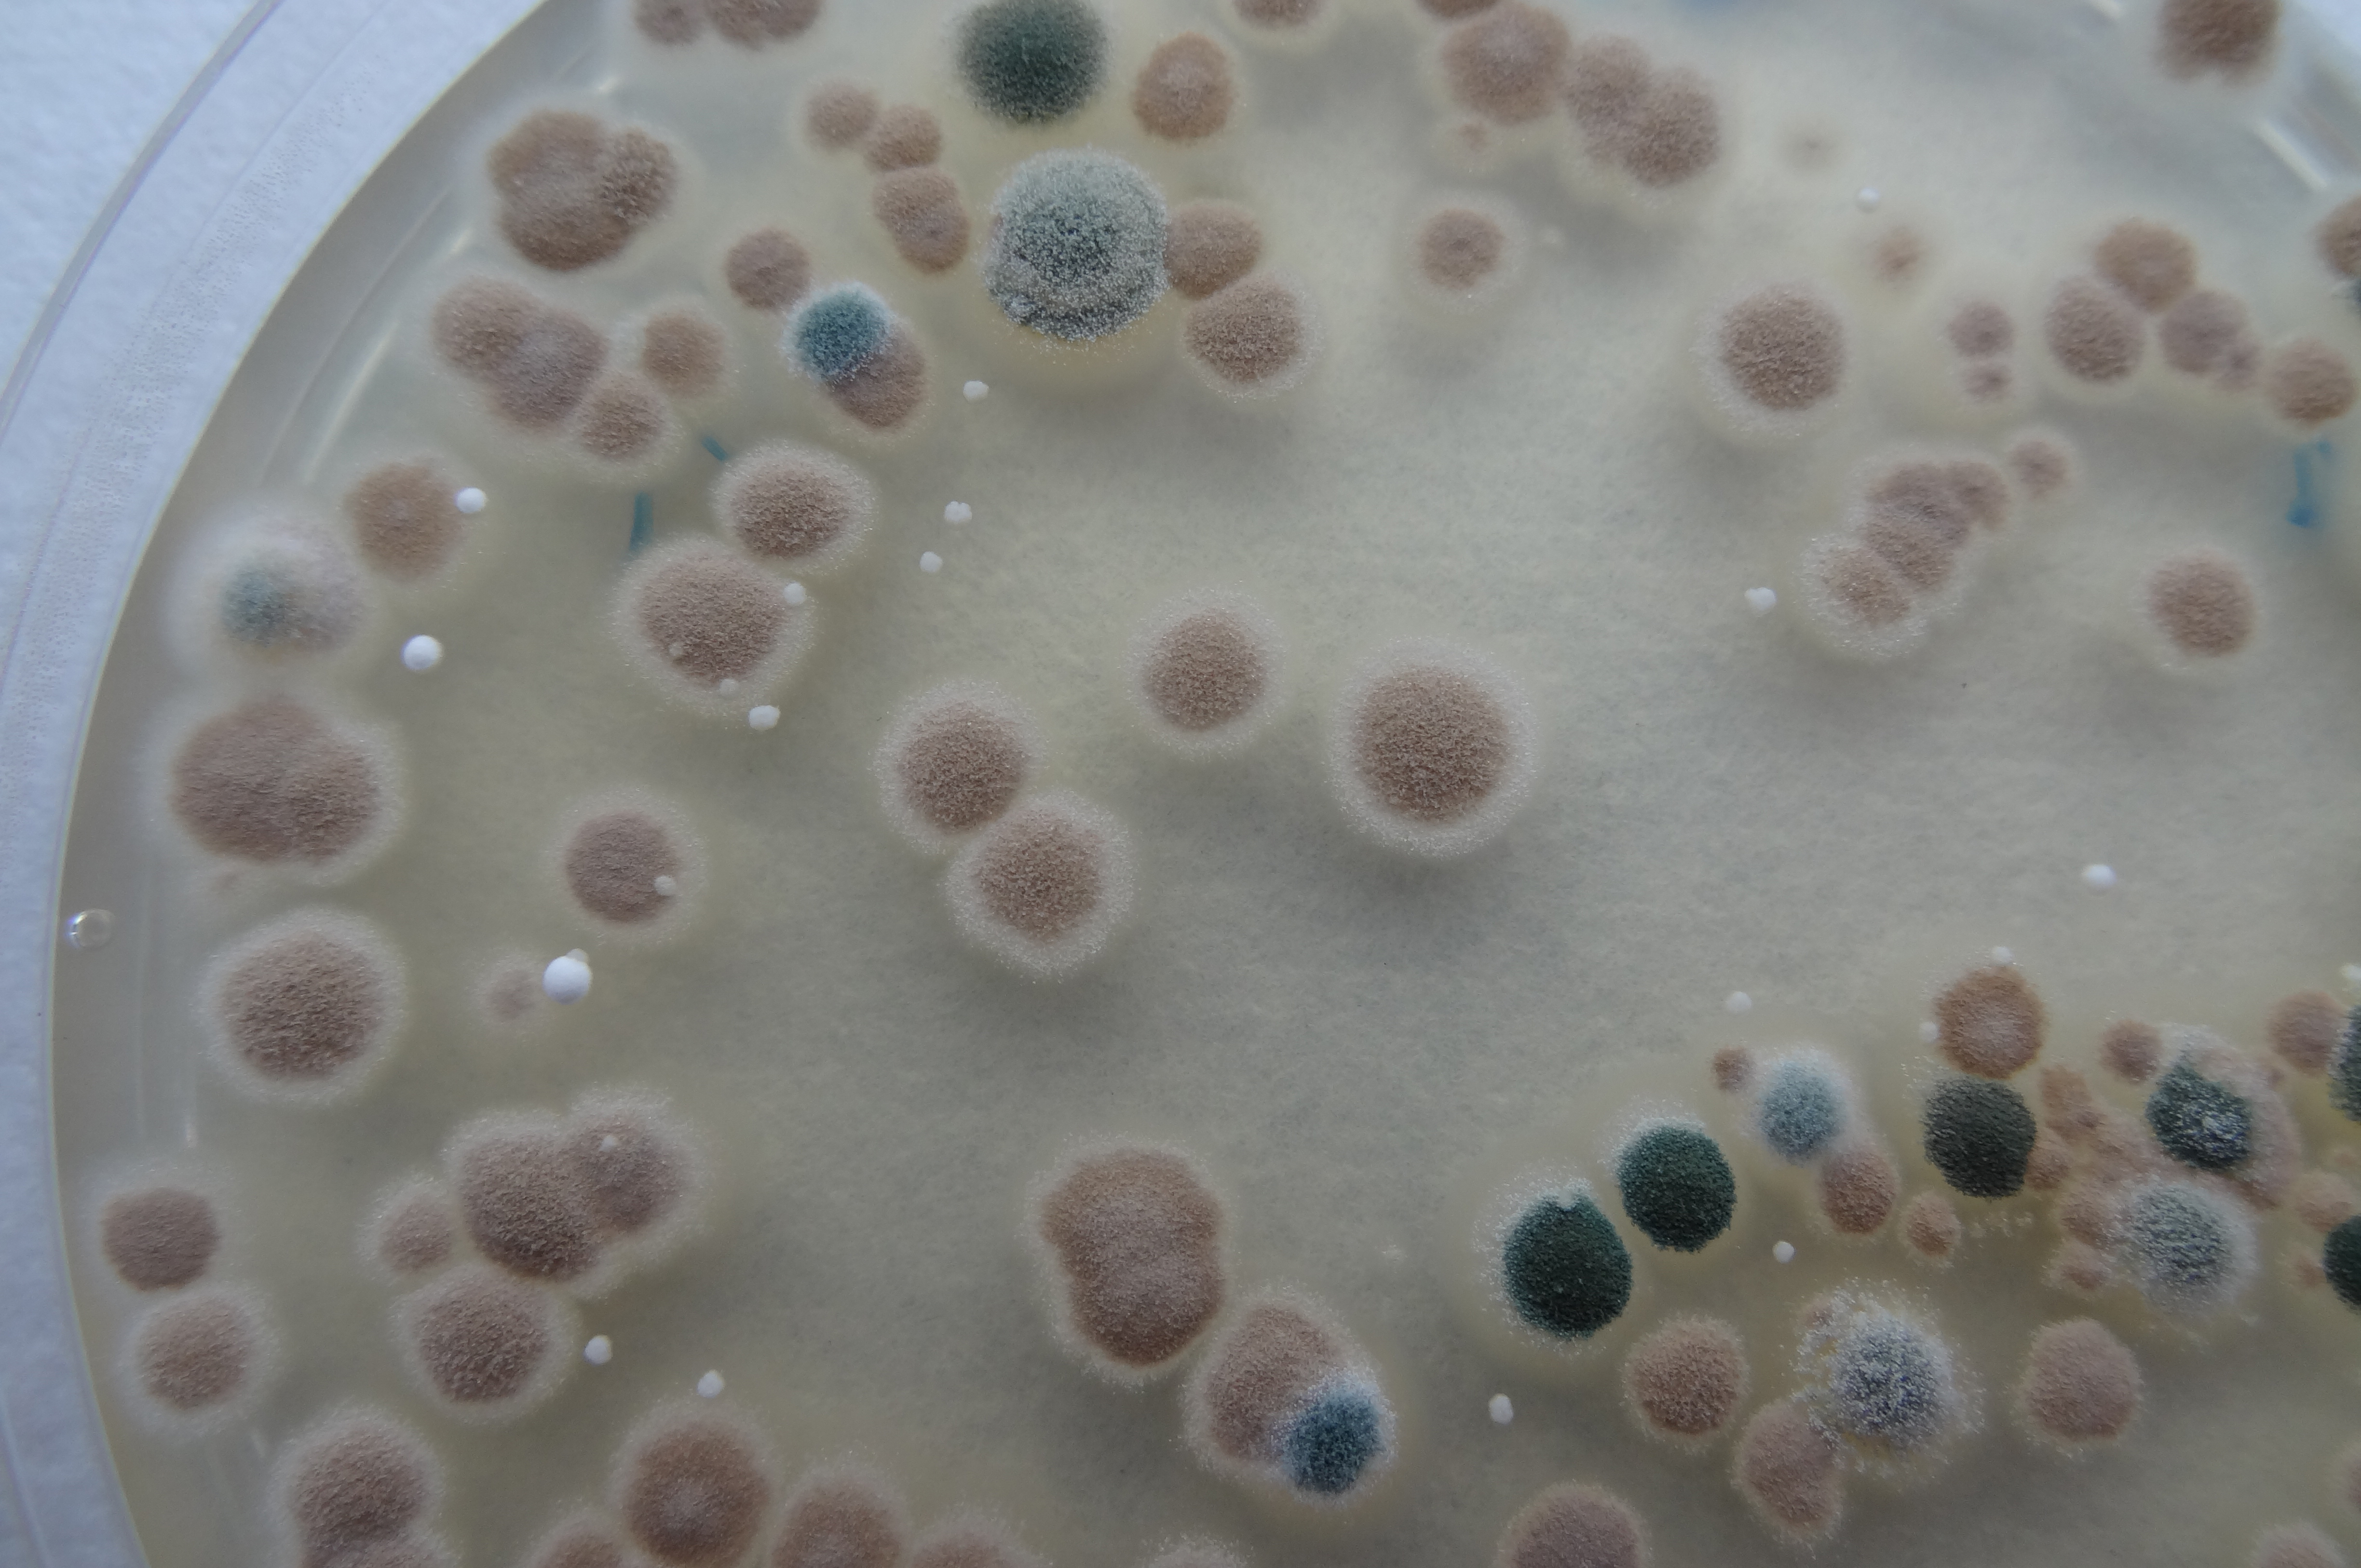
DSC03787.jpg DSC03787.jpg

GreenDezyme Biotech
GreenDezyme Biotech is a recombinant protein designing company specialized in producing particular enzymes upon request. The company also focuses on environmental protection issues and develops enzymes for kitchen and agricultural waste treatments.